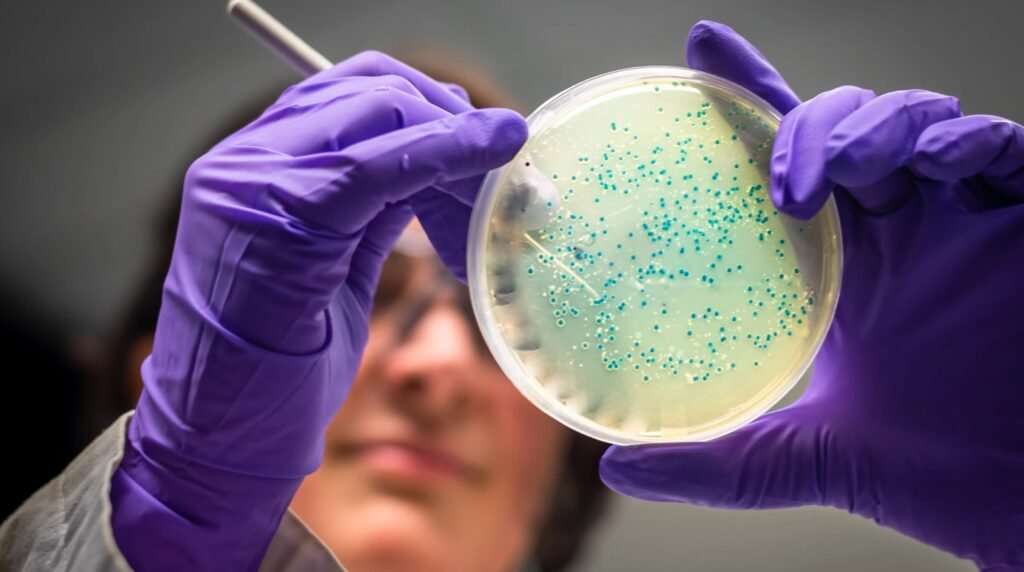

Once considered a niche topic, the gut microbiome has taken center stage in modern medicine. What was once the domain of specialized researchers and fringe nutrition experts has now become a core focus of global health conversations. From chronic disease prevention to mental health support, our intestinal bacteria are now seen as key players in how we function, heal, and thrive on a daily basis.
This growing attention isn’t just hype—it reflects decades of emerging science that connects gut health to nearly every major system in the body. We now understand that the trillions of microbes living inside our intestines aren’t passive passengers. They’re dynamic agents of change, shaping everything from our metabolism to our mood, from our immunity to our recovery after training or illness.
As a doctor, nutritionist, and sport trainer, I’ve watched this field evolve with both fascination and hope. These insights are not just theoretical—they’re transforming how we approach care, prevention, and performance in real life. For those looking to take control of their health in a more informed and personalized way, the gut may be the best place to start. The future of medicine may well begin in your gut. Here’s why.
Understanding your gut microbiome
The human microbiome is a collection of trillions of bacteria, viruses, and fungi living primarily in your gastrointestinal tract. These microbes don’t just coexist with us—they actively shape our digestion, immune response, and even hormone production. A healthy microbiome supports nutrient absorption and protects against harmful pathogens.
Recent research shows that the microbiome is as unique as a fingerprint. It’s influenced by diet, stress, medications, sleep, and physical activity. When its balance is disrupted—also known as dysbiosis—it can lead to inflammation, digestive issues, and broader systemic problems.
Gut health and chronic disease prevention

One of the most exciting breakthroughs in medicine is the link between microbiome diversity and chronic illness. Conditions like diabetes, obesity, cardiovascular disease, and autoimmune disorders have all been associated with gut imbalances. Some researchers now refer to the gut as an immune organ, given its deep influence on systemic inflammation.
Restoring microbial balance through targeted dietary changes and lifestyle adjustments may offer new pathways to disease prevention. While this is not a silver bullet, it’s becoming a vital part of personalized healthcare strategies worldwide.
The brain-gut connection: mood, focus, and sleep
The gut-brain axis—how your digestive tract communicates with your brain—is changing how we understand mental health. Certain gut bacteria produce neurotransmitters like serotonin, dopamine, and GABA, all essential for regulating mood, sleep, and cognitive function.
Emerging evidence suggests that improving gut health can alleviate symptoms of anxiety, depression, and even insomnia. In clinical settings, some mental health protocols now include nutritional interventions focused on restoring the microbiome.
Performance, recovery, and metabolism

In sports and fitness, gut health is becoming a key factor in performance and recovery. An optimized microbiome enhances nutrient absorption, reduces systemic inflammation, and supports a resilient immune system—all critical for athletes and active individuals.
For those pursuing body composition goals, gut bacteria also influence how we metabolize food and store fat. Certain strains may promote fat-burning pathways, while others are linked to insulin resistance. This makes microbiome health a powerful, and often overlooked, factor in sustainable weight management.
Everyday strategies to support your gut
- Eat a variety of plant-based foods to encourage microbial diversity
- Incorporate fermented foods like yogurt, kefir, and kimchi
- Avoid overuse of antibiotics and ultra-processed foods
- Get consistent, high-quality sleep
- Exercise regularly to support digestion and gut motility
These daily habits help create an environment in which beneficial microbes can thrive. Remember, gut health is less about quick fixes and more about long-term consistency.
What you need to remember
The microbiome is no longer just a side note in nutrition—it’s becoming a central focus in how we prevent disease, support mental health, and enhance physical performance. Its complexity is vast, but its importance is undeniable.
By caring for your gut with smart lifestyle choices, you’re investing in a future where medicine works with your body, not against it. And that future is already unfolding—one microbe at a time.